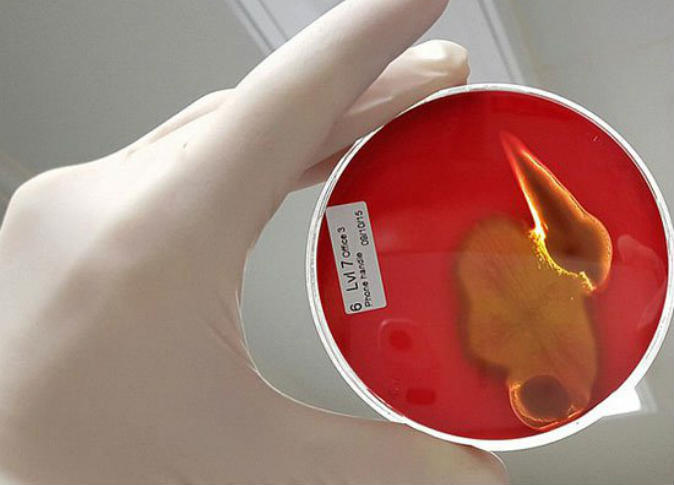
alsharq

أعلنت اللجنة الدائمة الموحدة لاختيار مرشحي ضباط الجهات العسكرية، عن فتح باب التسجيل للكليات العسكرية والأمنية لحملة الشهادة الثانوية العامة وما يعادلها للعام...
رئيس مجلس الإدارة : د. خالد بن ثاني آل ثاني

رئيس التحرير: جابر سالم الحرمي

مساحة إعلانية
مساحة إعلانية
صحة وأسرة
1313
بالصور.. أماكن العمل محاطة بملايين من البكتيريا الخطيرة
كشفت دراسة علمية حديثة عن وجود ملايين من البكتيريا الخطيرة للغاية قد تنتقل في أكثر من منطقة غير صحية في أماكن العمل، مثل الأسطح وهاتف المكتب وشاشة الهاتف المحمول والكيبورد.
.jpg)
ووجد الباحثون من جامعة كوينزلاند صورا مروعة من البكتيريا الموجودة على جميع أنحاء المكتب، وعلى مقابض الأبواب والمكاتب والكراسي.
.jpg)
وقال كبير الباحثين الدكتور داى كوبر من مركز كوينزلاند في أستراليا، إن أفضل طريقة لتجنب البكتيريا من خلال استخدام الصابون والماء بدلا من استخدام سائل مضاد للبكتيريا.
.jpg)
وأوضح كوبر أن الصابون والماء هو حل عملي ورخيص وأكثر فعالية إذا أردنا رفع مستوى الوعي، حيث إن هناك بكتيريا في كل مكان، والكثير من المواد المعقمة لليدين قد تكون غير متوفرة دائماً في العمل.
.jpg)
وعلى الرغم من أن العديد من المنظفات قد تستخدم شعار "يقتل 99.9% من الجراثيم"، إلا أنه مجرد شعار، وفقا لــ"كوبر".
اقرأ أيضاً
أخبار ذات صلة
مساحة إعلانية
مساحة إعلانية
الأكثر مشاهدة

أكد رامز الخياط، الرئيس التنفيذي لمجموعة باور إنترناشونال القابضة والرئيس التنفيذي في شركة أورباكون القابضة أن مشروعي شركاته في تطوير وتشغيل مطار دمشق...
5142
| 24 يناير 2026

أعلنت إدارة الأرصاد الجوية، التابعة للهيئة العامة للطيران المدني، أن آخر الصور الجوية توضح اقتراب كتلة غبارية من أجواء البلاد، ومن المتوقع أن...
4604
| 25 يناير 2026

شهدت محافظة القليوبية شمال مصر، اليوم الجمعة، حادثًا مأساويًا أدى إلى وفاة أم وأطفالها الأربعة نتيجة استنشاق الغاز داخل منزلهم بمنطقة أم بيومي...
4132
| 23 يناير 2026
مساحة إعلانية
مساحة إعلانية
الشرق الإقتصادي

أكد بيوش جويال وزير التجارة والصناعة الهندي، أن الهند والاتحاد الأوروبي يستعدان بعد غد /الثلاثاء/ للإعلان عن اختتام المفاوضات واللمسات النهائية لاتفاقية التجارة...
60
| 25 يناير 2026

بحثت الهيئة العامة للجمارك مع وفد من هونغ كونغ سبلالاعتراف المتبادل لبرنامج المشغل الاقتصادي المعتمدبين الجانبين، وذلك خلال استقبال طلال عبدالله الشيبي مساعد...
100
| 25 يناير 2026

وقعت مجموعة البنك الدولي وصندوق قطر للتنمية اليوم مذكرة تفاهم خلال حفل الافتتاح الرسمي لأول مكتب لمجموعة البنك الدولي في دولة قطر، والذي...
230
| 25 يناير 2026

اجتمع سعادة الشيخ بندر بن محمد بن سعود آل ثاني، محافظ مصرف قطر المركزي رئيس مجلس إدارة جهاز قطر للاستثمار اليوم، مع سعادة...
102
| 25 يناير 2026
مساحة إعلانية

حمل تطبيق الشرق
تابع الأخبار المحلية والعالمية من خلال تطبيقات الجوال المتاحة على متجر جوجل ومتجر آبل
آخر المقالات
-
إنجاز جديد يعزز مكانة قطر الريادية

رأي الشرق
-
تأثير الحروب على تنمية الدول

أ.د. أحمد أويصال
-
العلمانيون العرب.. مشروع وطني أم مشروع عمالة؟

أحمد المعاضيد
-
قطر الآمنة المُستأمنة

ابتسام آل سعد
الأكثر رواجاً
- 1 الأرصاد الجوية تحذر من من أمطار رعدية ورياح قوية
حذرت إدارة الأرصاد الجوية من أمطار رعدية متوقعة ورياح قوية ورؤية أفقية متدنية على الساحل، ومن أمطار رعدية متوقعة ورياح قوية وأمواج عالية...
3924
| 25 يناير 2026
- 2 البلدية تعلن إغلاق هايبر ماركت شهير 30 يوماً
أعلنت وزارة البلدية عن إغلاق هايبر ماركت لمخالفته قانون تنظيم الأغذية الآدمية رقم 8 لسنة 1990 بشأن تنظيم مراقبة الأغذية الآدمية المعدل بالقانون...
3272
| 25 يناير 2026
- 3 وزارة الأوقاف تعلن بدء التسجيل في المسابقة المدرسية السنوية لحفظ القرآن الكريم
أعلنت وزارة الأوقاف والشؤون الإسلامية، بالتعاون مع وزارة التربية والتعليم والتعليم العالي، عن فتح باب التسجيل للمشاركة في المسابقة المدرسية السنوية لحفظ القرآن...
2636
| 24 يناير 2026








